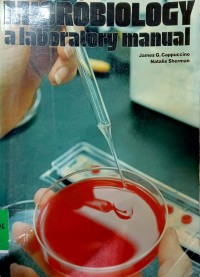
Microbiology : A Laboratory Manual

Text
Microbiology : A Laboratory Manual
Tidak Tersedia Deskripsi
Ketersediaan
#
Perpustakaan Pusat (576)
576.076 CAP m
B005280
Tersedia
#
Perpustakaan Pusat (576)
576.076 CAP m
B005529
Tersedia
Informasi Detail
- Judul Seri
-
-
- No. Panggil
-
576.076 CAP m
- Penerbit
- Massachusetts : Addison-Wesley Publishig Compay.,
- Deskripsi Fisik
-
xiii, 466 hlm,ilu, 21x28 cm.
- Bahasa
-
English
- ISBN/ISSN
-
0-201-11160-8
- Klasifikasi
-
576.076
- Tipe Isi
-
text
- Tipe Media
-
-
- Tipe Pembawa
-
-
- Edisi
-
Ed. 1
- Subjek
- Info Detail Spesifik
-
-
- Pernyataan Tanggungjawab
-
James G. Cappuccino
Versi lain/terkait
Tidak tersedia versi lain
Lampiran Berkas
Tidak Ada Data
Komentar
Anda harus masuk sebelum memberikan komentar
Karya Umum
Karya Umum  Filsafat
Filsafat  Agama
Agama  Ilmu-ilmu Sosial
Ilmu-ilmu Sosial  Bahasa
Bahasa  Ilmu-ilmu Murni
Ilmu-ilmu Murni  Ilmu-ilmu Terapan
Ilmu-ilmu Terapan  Kesenian, Hiburan, dan Olahraga
Kesenian, Hiburan, dan Olahraga  Kesusastraan
Kesusastraan  Geografi dan Sejarah
Geografi dan Sejarah